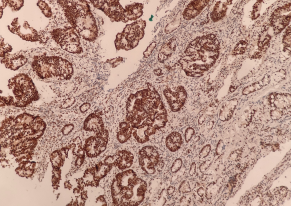

病理诊断是临床诊疗的“金标准”,而免疫组化染色的精准度与稳定性,直接决定了诊断结论的可靠性与诊疗方案的适配性。
天津某三甲医院病理科日常需承接乳腺癌、结直肠癌、血液肿瘤等多类病症的标本检测,在实践中,科室面临着一项关键挑战:血液、骨髓样本染色时易出现背景杂色干扰,目标蛋白定位精准度不足,这不仅增加了诊断医师的判读难度,也在一定程度上影响了报告出具的效率与质量。
为针对性破解这一临床痛点,天津某医院病理科经过多维度考察与技术评估,最终选择引入达科为NS40全自动免疫组化染色机开展试用,期望通过专业化设备的赋能,实现染色质量的全面提升。
达科为全自动免疫组化染色机NS40
搭配高灵敏度自研二抗染色系统
在天津某三甲医院病理科正式投入使用
👇

试用期间,凭借全自动免疫组化染色机NS40稳定可靠的性能表现、产品团队专业的试剂技术支持,达科为交出了让客户满意的答卷。
在多项核心诊断指标的染色测试中,其表现呈现出显著优势:

PMS2
MLH1

HER2

CD34

Ki67
除核心染色性能外,全自动免疫组化染色机NS40的人性化功能设计也与科室实际工作场景高度契合。
技术组长反馈:“盖板质控追溯功能极具实用价值。此前新人操作时偶有忘记放置盖板、或者盖板破损忘记更换的情况,如今通过二维码溯源机制,可及时发现盖板问题并进行调整,既降低了人为失误发生率,也推动科室质量管理体系更趋完善。”

同时,设备采用简洁直观的UI操作界面,医护人员经基础培训即可快速掌握核心操作,顺利融入日常诊疗流程,实现了技术升级与工作效率的同步提升。

全自动免疫组化染色机NS40搭配高质量自研二抗染色系统,以临床应用为导向,聚焦染色准确性、设备稳定性与操作规范易用等临床核心诉求,高效解决病理科室实际痛点,凭借扎实的技术表现获得了天津某三甲医院病理科的认可。
达科为将持续以专业技术赋能病理诊断,让每一次染色结果都精准可控,为临床诊疗决策筑牢坚实基础。
